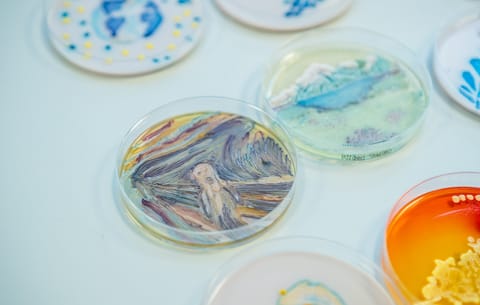

8 híres művész, aki megjárta a poklok poklát és közben maradandót alkotott
A legnagyobb művészek állítólag sosem az átlagemberek közül kerülnek ki. Sokkal inkább azok közül, akik a boldogságot csak ritkán érintve, egyfajta lelki hullámvasúton utaznak az életükben. Ugyanakkor a depresszió hajtómotor is tud lenni, még ha a poklok poklát járja is az illető. Nyolc híres művész, akit nem kímélt a mentális kór.